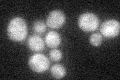
YER075C
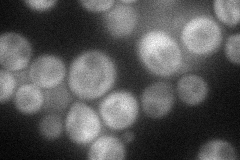
YER075C
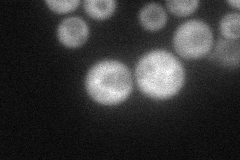
YER075C
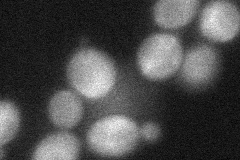
YER075C
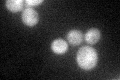
YER075C
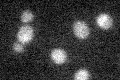
YER075C

View description
Phosphotyrosine-specific protein phosphatase involved in the inactivation of mitogen-activated protein kinase (MAPK) during osmolarity sensing; dephosporylates Hog1p MAPK and regulates its localization; localized to the cytoplasm
Localization:
Intensity:
Fold change:
Significance:
-
C’ GFP library in SD
cytosol24.72 -
N' NOP1pr-GFP in SD
cytosol54.4131 -
N' TEF2pr-mCherry in SD
cytosol44.092 -
N' NATIVEpr-GFP in SD

below threshold22.3955 -
N' TEF2pr-VC and Cyto-VN in SD
cytosol39.2229 -
C’ GFP library in SD+DTT
cytosol25.251.02No -
C’ GFP library in SD+H2O2

cytosol27.781.12No -
C’ GFP library in Starvation Media
cytosol19.880.8No -
C’ GFP library on the background of Pup2-DaMP

cytosol -
C’ GFP library on the background of CCT mutant

cytosol25.80691.04356No
